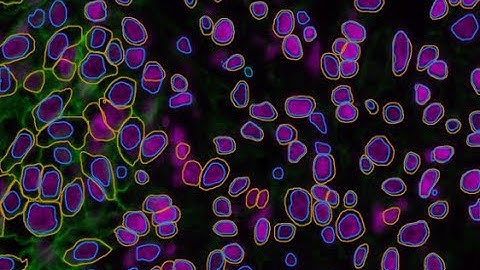
DeepCSeg: Deep learning cell segmentation

⬇ DOWNLOAD NOW
Jika muncul iklan pop-up, tutup lalu klik tombol kembali
Download lagu HistoFlow: Label-Efficient and Interactive Deep Learning Cell Segmentation and Analysis secara gratis hanya untuk keperluan promosi. Dukung artis favorit kamu dengan membeli musik original di iTunes atau platform resmi lainnya.
 AI-Driven, Label-Free Quantification of Cell Viability in Live-Cell Imaging
AI-Driven, Label-Free Quantification of Cell Viability in Live-Cell Imaging BioTuring Lens: A Deep Learning Platform for Accurate Cell Segmentation
BioTuring Lens: A Deep Learning Platform for Accurate Cell Segmentation Cell Segmentation: Automate Analysis with AI & Computer Vision
Cell Segmentation: Automate Analysis with AI & Computer Vision Capturing Cellular Topology in Multi-Gigapixel Pathology Images
Capturing Cellular Topology in Multi-Gigapixel Pathology Images Label-Free Quantification of Cell Growth and Morphology Using AI and Advanced Data Analytics
Label-Free Quantification of Cell Growth and Morphology Using AI and Advanced Data Analytics Data-Efficient Deep Learning Framework for Segmentation and Classification of Histopathology Images
Data-Efficient Deep Learning Framework for Segmentation and Classification of Histopathology Images Deep Learning for Cell Imaging Segmentation - Lecture 20 - MIT ML in Life Sciences (Spring 2021)
Deep Learning for Cell Imaging Segmentation - Lecture 20 - MIT ML in Life Sciences (Spring 2021) DeepCSeg: Deep learning cell segmentation
DeepCSeg: Deep learning cell segmentation